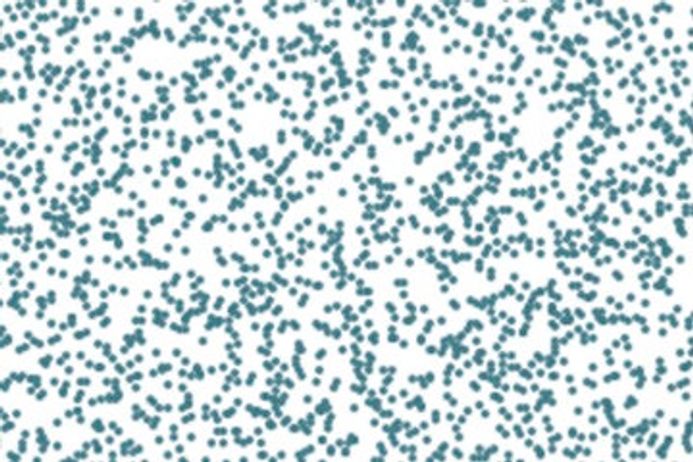

Research
PhD opportunities
We offer a wide range of PhD opportunities in our research area, including in Theoretical Physics PhD and in Astrophysics. All applications should be made online via the postgraduate applications system My Imperial.
Our research areas
Research in the Science of Universe community encompasses activity from our Astrophysics and Theoretical Physics research groups.